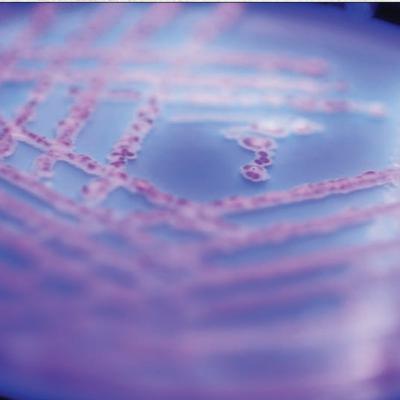
Molecular Cloning Methods (CMB part 2) Molecular Cloning Methods (CMB part 2)

Discover
Cellular and Molecular Biology for Research
Cellular and Molecular Biology for Research
Author: Ahmadreza Gharaeian
Subscribed: 29Played: 87Subscribe
Share
© Ahmadreza Gharaeian
Description
Cellular and Molecular Biology for Research is the podcast where complex textbooks stop gathering dust and start making sense. Each episode breaks down the dense chapters of cellular and molecular biology—DNA, signaling pathways, protein folding, experimental techniques—into clear explanations for students, early-career researchers, or anyone who wants to actually understand the science instead of just memorizing it. Think of it as your study buddy who reads the heavy stuff, translates the jargon, and hands you the key concepts (with a little less pain and a lot more clarity).
30 Episodes
Reverse
Eukaryotic activators consist of at least two domains: a DNA-binding domain and a transcription-activating domain. DNA-binding domains include motifs such as zinc modules, homeodomains, bZIP, or bHLH motifs. Transcription-activating domains can be acidic, glutamine-rich, or proline-rich. Zinc fingers are characterized by an antiparallel β-sheet followed by an α-helix. The β-sheet contains two cysteines, and the α-helix contains two histidines, which coordinate with a zinc ion to form the finger-shaped structure. This coordination facilitates specific recognition of the DNA target within the major groove.The DNA-binding motif of the GAL4 protein includes six cysteines that coordinate two zinc ions in a bimetal thiolate cluster. This motif features a short α-helix that extends into the DNA major groove, forming specific interactions. Additionally, the GAL4 monomer contains an α-helical dimerization motif that forms a parallel coiled coil with the α-helix of another GAL4 monomer. Type I nuclear receptors are located in the cytoplasm, bound to other proteins. Upon binding their hormone ligands, these receptors release their cytoplasmic partners, translocate to the nucleus, bind to enhancers, and function as activators. A representative example is the glucocorticoid receptor, which contains a DNA-binding domain with two zinc modules. One module provides DNA-binding residues in a recognition α-helix, while the other facilitates protein-protein interactions for dimer formation. These zinc modules use four cysteine residues to complex the zinc ion, unlike classical zinc fingers, which use two cysteines and two histidines.Homeodomains in eukaryotic activators contain a DNA-binding motif that operates similarly to the helix-turn-helix motifs in prokaryotes, where a recognition helix fits into the DNA major groove.
Transcription factors bind to class II promoters in vitro in the following sequence: (1) TFIID, with assistance from TFIIA, attaches to the TATA box. (2) TFIIB binds subsequently. (3) TFIIF facilitates the binding of RNA polymerase II. The remaining factors bind in this order:IIE and TFIIH, creating the DABPolFEH preinitiation complex. Notably, TFIIA's involvement appears to be optional in vitro.TFIID is composed of a TATA-box-binding protein (TBP) and 13 additional polypeptides referred to as TBP-associated factors (TAFs). The TATA-box-binding domain of TBP is located within its C-terminal 180 amino acid fragment. The interaction between TBP and the TATA box occurs within the DNA minor groove. The saddle-like shape of TBP aligns with the DNA, and the underside of the "saddle" forces the minor groove open, bending the TATA box by approximately 80 degrees. TBP is essential for the transcription of most genes across all three classes, not limited to class II genes.Many TAFs are evolutionarily conserved across eukaryotes and serve multiple roles, including interacting with core promoter elements and gene-specific transcription factors. TAF1 and TAF2 enable TFIID to bind to initiator elements and downstream promoter elements (DPEs), allowing TBP to bind to certain TATA-less promoters. TAF1 and TAF4 facilitate TFIID's interaction with Sp1 bound to GC boxes upstream of the transcription start site, ensuring TBP binding to TATA-less promoters containing GC boxes. Different TAF combinations are required to respond to various transcription activators, particularly in higher eukaryotes. Additionally, TAF1 exhibits enzymatic activity as both a histone acetyltransferase and a protein kinase. However, TFIID is not universally required in higher eukaryotes. For instance, some Drosophila promoters require an alternative factor, TRF1, while others depend on a TBP-free TAF complex.
Eukaryotic nuclei house three distinct RNA polymerases, which can be separated using ion-exchange chromatography. RNA polymerase I resides in the nucleolus, while other two are located in the nucleoplasm. Each of these polymerases performs specific transcriptional roles. Polymerase I synthesizes a large precursor to the major rRNAs (5.8S, 18S, and 28S in vertebrates). Polymerase II generates hnRNAs, precursors to mRNAs, as well as miRNA precursors and most small nuclear RNAs (snRNAs). Polymerase III is responsible for producing precursors of 5S rRNA, tRNAs, and various other small cellular and viral RNAs.The subunit structures of the three nuclear polymerases have been analyzed in several eukaryotes, revealing multiple subunits, including two large ones exceeding 100 kD in molecular mass. Common subunits appear in all three polymerases across eukaryotes. In yeast, the genes encoding all 12 RNA polymerase II subunits have been sequenced and subjected to mutation analysis. Among these subunits, three resemble the core subunits of bacterial RNA polymerases in structure and function, five are shared by all three nuclear polymerases, two are dispensable under normal conditions, and two do not fit into these categories.Subunit IIa, the primary product of the yeast RPB1 gene, can be converted to IIb in vitro through the proteolytic removal of the carboxyl-terminal domain (CTD), which consists of repeated heptapeptides. In vivo, subunit IIa is phosphorylated at two serines within the CTD heptad to form IIo. The enzyme containing the IIa subunit (polymerase IIA) binds to the promoter, while the enzyme with the IIo subunit (polymerase IIO) participates in transcript elongation.The structure of yeast pol II D4/7 reveals a deep cleft capable of accommodating a DNA template. The catalytic activity and functional mechanisms of these polymerases underscore their critical roles in eukaryotic transcription.
The repressors of the λ-like phages possess recognition helices that fit sideways into the major groove of the operator DNA. Specific amino acids on the DNA-facing side of the recognition helix establish precise contacts with bases in the operator, and these interactions determine the specificity of the protein-DNA binding. Altering these amino acids can modify the specificity of the repressor. Both the λ repressor and the Cro protein exhibit affinity for the same operators, but their microspecificities for OR1 or OR3 are defined by interactions between distinct amino acids in the recognition helices of the two proteins and the base pairs in the respective operators. The cocrystal structure of a λ repressor fragment bound to an operator fragment provides detailed insight into the protein-DNA interactions. The most critical contacts occur in the major groove, where amino acids on the recognition helix, along with other amino acids, form hydrogen bonds with the edges of DNA bases and the DNA backbone. Some of these hydrogen bonds are reinforced by hydrogen bond networks involving two amino acids and multiple sites on the DNA. The structural data derived from the cocrystal closely align with prior biochemical and genetic findings.X-ray crystallography of a phage 434 repressor fragment/operator-fragment complex reveals probable hydrogen bonding between amino acid residues in the recognition helix and base pairs in the repressor. It also indicates a potential van der Waals interaction between an amino acid in the recognition helix and a base in the operator. The DNA in the deviates significantly from its typical regular shape, bending slightly to facilitate the necessary base/amino acid contacts. Additionally, the central region of the helix, the two half-sites, is wound more tightly, while the outer regions are wound more loosely than usual. These structural deviations are supported by the base sequence of the operator.
Bacteria undergo significant shifts in transcription patterns during various processes, such as phage infection or sporulation, and have evolved multiple mechanisms to facilitate these changes. For instance, the transcription of phage SPO1 genes in infected B. subtilis cells follows a temporal sequence, where early genes are transcribed first, followed by middle genes, and finally late genes. This transition is regulated by phage-encoded sigma factors that associate with the host's core RNA polymerase and alter its specificity from early to middle to late genes. The host sigma factor is specific to the phage early genes, while the phage gp28 protein changes the specificity to middle genes, and gp33 and gp34 proteins direct specificity to late genes.When B. subtilis undergoes sporulation, an entirely new set of sporulation-specific genes is activated, while many vegetative genes are turned off. This switch primarily occurs at the transcriptional level and is mediated by several new sigma factors that displace the vegetative sigma factor from the core RNA polymerase, redirecting transcription to sporulation-specific genes. Each sigma factor recognizes its own preferred promoter sequence.Certain prokaryotic genes must be transcribed under conditions where two different sigma factors are active. These genes are equipped with dual promoters, each recognized by one of the sigma factors, ensuring their expression regardless of which factor is present and enabling differential regulation under varying conditions. For example, in E. coli, the heat shock response and responses to low nitrogen and starvation stress are regulated by alternative sigma factors—sigma32 (σH), sigma54 (σN), and sigma38 (σS)—which replace the primary sigma factor sigma70 (σA) and direct RNA polymerase to alternative promoters. Additionally, many sigma factors are regulated by anti-sigma factors that bind to specific sigma factors and inhibit their interaction with the core RNA polymerase. Some of these anti-sigma factors are further regulated by additional mechanisms.
Lactose metabolism in E. coli is facilitated by two essential proteins, β-galactosidase and galactoside permease. The genes encoding these proteins, along with another enzyme, are organized into a cluster and transcribed together from a single promoter, producing a polycistronic mRNA. These functionally related genes are therefore regulated collectively. The lac operon is controlled through both positive and negative regulatory mechanisms. Negative regulation occurs as follows: the operon remains inactive when the repressor binds to the operator, blocking RNA polymerase from attaching to the promoter and transcribing the three lac genes. When glucose is depleted and lactose becomes available, the few existing molecules of lac operon enzymes convert lactose into allolactose, which functions as an inducer. Allolactose binds to the repressor, inducing a conformational change that prompts its dissociation from the operator. Once the repressor is removed, RNA polymerase can proceed to transcribe the three lac genes. Genetic and biochemical studies have identified the two primary components of negative control in the lac operon: the operator and the repressor. Additionally, DNA sequencing has revealed two auxiliary lac operators, one upstream and one downstream of the main operator, all three of which are necessary for optimal repression.Positive regulation of the lac operon, as well as other inducible operons encoding sugar-metabolizing enzymes, is mediated by the catabolite activator protein (CAP) in conjunction with cyclic AMP (cAMP). The CAP-cAMP complex enhances transcription. However, glucose suppresses cAMP levels, thereby inhibiting positive regulation. As a result, the lac operon becomes active only when glucose levels are low, necessitating the metabolism of an alternative energy source. The CAP-cAMP complex facilitates this activation.
The catalytic agent in the transcription process is RNA polymerase. In E. coli, this enzyme consists of a core, which houses the fundamental transcription machinery, and a sigma factor (σ-factor), which guides the core to transcribe specific genes. The σ-factor facilitates the initiation of transcription by enabling the RNA polymerase holoenzyme to bind tightly to a promoter. This σ-dependent binding necessitates the localized melting of 10–17 base pairs of DNA near the transcription start site, forming an open promoter complex. By directing the holoenzyme to bind exclusively to certain promoters, the σ-factor determines which genes will be transcribed. Transcription initiation proceeds until 9 or 10 nucleotides are incorporated into the RNA, at which point the core transitions to an elongation-specific conformation, departs from the promoter, and continues with elongation. The σ-factor is generally released from the core polymerase, though not always immediately after promoter clearance, often exiting stochastically during elongation. The σ-factor can be reused by other core polymerases. Rifampicin sensitivity or resistance is governed by the core, not the σ-factor. E. coli RNA polymerase achieves abortive transcription through a mechanism called scrunching, in which downstream DNA is drawn into the polymerase without the polymerase physically moving, while retaining its grip on the promoter DNA. The scrunched DNA may store sufficient energy to enable the polymerase to dissociate from the promoter and initiate productive transcription. Prokaryotic promoters contain two key regions located approximately 10 and 35 base pairs upstream of the transcription start site. In E. coli, these regions have consensus sequences of TATAAT and TTGACA, respectively. Generally, the closer a promoter's sequences match these consensus sequences, the stronger the promoter will be. Some exceptionally strong promoters also feature an additional element, known as an UP element, upstream of the core promoter.
Methods for purifying proteins and nucleic acids are fundamental in molecular biology. DNA, RNA, and proteins of varying sizes can be effectively separated using gel electrophoresis. Agarose is the most commonly used gel for nucleic acid electrophoresis, while polyacrylamide is typically employed for protein electrophoresis. Sodium dodecyl sulfate polyacrylamide gel electrophoresis (SDS-PAGE) separates polypeptides based on their sizes. For higher resolution, two-dimensional gel electrophoresis is utilized, combining isoelectric focusing in the first dimension with SDS-PAGE in the second. Ion-exchange chromatography is another technique that separates substances, including proteins, according to their charges, often employing positively charged resins like DEAE-Sephadex.Labeled DNA or RNA probes can be hybridized to DNAs with identical or very similar sequences on a Southern blot. Modern DNA typing employs Southern blots and multiple DNA probes to detect variable sites in individual organisms, including humans. Additionally, labeled probes may be hybridized to entire chromosomes to identify specific genes or DNA sequences, a process known as in situ hybridization, or fluorescence in situ hybridization (FISH) when fluorescently labeled probes are used. Proteins in complex mixtures can be detected and quantified using immunoblots, or Western blots, where proteins are electrophoresed, transferred to a membrane, and probed with specific antibodies detected via labeled secondary antibodies or protein A.The Sanger DNA sequencing method relies on dideoxy nucleotides to terminate DNA synthesis, producing DNA fragments of varying sizes that can be analyzed by electrophoresis. The last base of each fragment is determined by the specific dideoxy nucleotide used to terminate the reaction, enabling fragments to be ordered by size, with each one being a single, known base longer than the previous.
To clone a gene, it must be inserted into a vector capable of carrying the gene into a host cell and ensuring its replication. This insertion is typically achieved by cutting both the vector and the target DNA with the same restriction endonucleases to create matching “sticky ends.” Cloning vectors in bacteria are primarily categorized as plasmids or phages. Plasmid cloning vectors include pBR322 and the pUC plasmids. The pUC plasmids and pBS phagemids facilitate convenient screening, as they possess an ampicillin resistance gene and a multiple cloning site that disrupts a partial β-galactosidase gene. The resulting clones are resistant to ampicillin and lack active β-galactosidase, which is easily identifiable through a color test. Two prominent types of phage vectors are widely used in cloning. The first is λ (lambda), which has had nonessential genes removed to accommodate inserts, allowing for the insertion of up to 20 kb. Cosmids, combining features of phage and plasmid vectors, can accept inserts up to 50 kb, making them ideal for constructing genomic libraries. The second major type is M13 phages, which offer a multiple cloning region and the ability to produce single-stranded recombinant DNA. This single-stranded DNA is particularly useful for sequencing and site-directed mutagenesis. Phagemids, plasmids with an origin of replication for single-stranded DNA phages, can also generate single-stranded copies of themselves. Expression vectors are specifically designed to maximize the production of a protein encoded by a cloned gene. Bacterial expression vectors optimize expression by incorporating strong bacterial promoters and ribosome-binding sites, which are typically absent in cloned eukaryotic genes. Most cloning vectors are inducible to control protein production efficiently.
The three primary functions of genes are storing information, replication, and the accumulation of mutations. Proteins, also known as polypeptides, are polymers of amino acids linked by peptide bonds. Most genes carry the instructions for producing a single polypeptide and are expressed through a two-step process: transcription, which synthesizes an mRNA copy of the gene, followed by translation, where this mRNA is used to produce a protein. Translation occurs on ribosomes, the cell’s protein factories, and requires transfer RNAs (tRNAs), which act as adapters capable of recognizing both the genetic code in mRNA and the corresponding amino acids.Translation elongation involves three key steps: (1) the transfer of an aminoacyl-tRNA to the A site, (2) the formation of a peptide bond between the amino acid at the P site and the aminoacyl-tRNA at the A site, and (3) the translocation of mRNA by one codon length through the ribosome, positioning the newly formed peptidyl-tRNA at the P site. Translation concludes at a stop codon (UAG, UAA, or UGA). A segment of RNA or DNA that includes a translation initiation codon, a coding region, and a termination codon is referred to as an open reading frame. The section of mRNA between its 5'-end and the initiation codon is called the leader or 5'-UTR, while the part between the 3'-end (or poly(A) tail) and the termination codon is referred to as the trailer or 3'-UTR.DNA replicates through a semiconservative mechanism: as the parental strands separate, each serves as a template for the synthesis of a new complementary strand. A mutation in a gene often leads to a change in the corresponding position within the polypeptide product. Sickle cell disease serves as an example of the harmful effects such mutations can cause.
Cancer is characterized as a malignant tumor, defined by its ability to grow progressively, invade surrounding healthy tissues, and spread to distant sites through a process known as metastasis. These malignant cells are essentially altered versions of the body’s own cells, having escaped normal growth-regulating mechanisms and apoptotic signals, which leads to unchecked proliferation.From an immunological standpoint, the immune system plays a vital role in cancer surveillance as part of its regular maintenance functions. However, cancer cells often develop mechanisms to escape immune detection. The interaction between cancer and the immune system is explained by a dynamic process called immunoediting, which occurs in three phases:Elimination: The immune system detects and eradicates newly formed cancer cells.Equilibrium: A state is reached where there is a balance between the immune-mediated destruction of neoplastic cells and the survival of a small population of cancer cells.Escape: The most aggressive and least immunogenic tumor cells proliferate and spread, often aided by immune pathways, after developing sophisticated strategies to bypass the immune response.Cancer cells express various tumor antigens that can be recognized by the immune system, which are categorized as follows:Tumor-specific antigens (TSAs): Unique proteins arising from DNA mutations or viral infections, resulting in novel, non-self peptides.Tumor-associated antigens (TAAs): Normal cellular proteins with abnormal expression patterns, such as embryonic proteins expressed in adults (oncofetal antigens) or overexpressed self-proteins.To evade immune responses, transformed cells utilize several strategies, including downregulation of MHC class I expression, resistance to apoptotic signals, and impaired or blocked costimulatory signals necessary for T-cell activation. These factors can contribute to the establishment of an immunosuppressive microenvironment around the tumor. Additionally, chronic inflammation can paradoxically foster a pro-tumor microenvironment by promoting mutation accumulation and enhancing tumor progression.
Immunodeficiency diseases underscore the critical role of the immune system's cells and molecules in maintaining overall protection against disease. Primary immunodeficiency diseases, stemming from over 300 distinct inherited genetic defects, encompass a spectrum from severe SCID conditions affecting T cells and B cells to milder defects impacting the production of specific immunoglobulin classes or complement components. The most severe SCID cases obstruct the development of all hematopoietic lineages, T and B cells, or T cells alone, which in turn impairs antibody production due to the essential roles of helper T cells in many antibody responses. Advances in early screening now enable the detection of most SCID forms at birth, allowing for infection prevention and timely initiation of therapies. Some of these defects can now be corrected through bone marrow or HSC transplantation, with gene therapy emerging as a promising avenue.Other primary immunodeficiencies that affect narrower aspects of the immune system, such as antibodies or complement components, may be more readily managed by replacing the missing immune protein through intravenous administration of immunoglobulins or complement components. However, reduced B or T cell counts can result in immune dysregulation, explaining the paradox of immunodeficiency coinciding with autoimmunity. More clearly defined are the mechanisms behind severe autoimmune conditions like APECED and IPEX, which arise from defects in self-tolerance within the thymus or in the generation of regulatory T cells.Secondary, or acquired, immunodeficiencies occur due to factors that negatively affect immune responses over the course of life, such as malnutrition, immunosuppressive drug treatments, or HIV infection. Various aspects of HIV epidemiology and biology have contributed to its significant global impact. For instance, HIV can be transmitted...
Infectious agents are incredibly diverse and resilient. These predominantly free-living organisms possess several advantages over their human hosts, including significantly more evolutionary time, shorter generational cycles, and extraordinary adaptability. As their hosts, humans also have notable strengths, such as a highly advanced system—comprising both innate and adaptive components—that has evolved through interactions with these infectious agents, both beneficial and harmful. Additionally, humans arguably hold intellectual and technological superiority, which we have effectively employed to combat these threats. From primitive yet effective measures to modern advancements like antibiotics and vaccines, we have achieved remarkable in saving lives, particularly those of young children. Nevertheless, the emergence and re-emergence of infectious diseases are likely to remain persistent challenges. Some of issues can be mitigated through reduced encroachment on animal habitats, efforts to counteract global warming, and improved sanitation practices. Moreover, the recent spread of Ebola to other continents serves as a stark warning: addressing the needs of those most affected by poverty and growing global inequities is a shared responsibility, one that no physical barrier can resolve.
Significant progress has been made in understanding the principles of immune tolerance over the past decade. Previously, tolerance was primarily perceived as the complete elimination of autoreactive cells, adhering to the “ignorance is bliss” model. However, current insights reveal a more intricate understanding of tolerance. Scientists now recognize that while certain structures remain hidden from the immune system’s surveillance (evasion), and the most aggressive anti-self lymphocytes are eliminated (elimination), specific self-recognizing regulatory lymphocytes play a critical role in suppressing anti-self immune responses (engagement). The absence of this regulatory component disrupts the delicate equilibrium. Both central and peripheral tolerance mechanisms have been elucidated through animal models and are now being utilized to manipulate immune tolerance in humans. Various immunotherapeutic approaches are employed to treat autoimmune diseases and prevent immune rejection of allografts, showcasing some of the most promising applications of immune tolerance principles from research to clinical practice.
Immune responses are often a double-edged sword. Their essential role in protecting against infections is critical for survival, as shown by the fatal consequences of untreated immunodeficiency diseases (to be discussed in Chapter 18). To ensure effective protection, a broad range of innate and adaptive immune mechanisms has evolved, typically enabling responses tailored to the specific pathogen entering the body. However, immune responses are inherently destructive, and when excessive, persistent, or misdirected, they can harm the body. This chapter has focused on such conditions, including the four classes of hypersensitivity reactions and chronic inflammation.Type I hypersensitivity reactions, commonly known as allergies, are mediated by IgE antibodies bound to FcεRI receptors on mast cells, basophils, and eosinophils, which become cross-linked by recognized antigens. This triggers degranulation, releasing mediators responsible for allergy symptoms. These symptoms may manifest locally, such as in the respiratory tract for airborne allergens or in the gastrointestinal tract for food allergens, but they can also be systemic if the allergen enters the bloodstream, as with insect stings, drugs like penicillin, and certain foods. Although IgE and granulocyte degranulation likely evolved to combat parasitic worms and animal or insect venoms, some allergic reactions, such as hay fever, are mostly inconveniences, while others, like anaphylaxis and asthma, are maladaptive and potentially life-threatening.Type II and Type III hypersensitivity reactions involve normal IgM and IgG antibody-antigen interactions that become harmful when excessive or misdirected. Type II reactions arise from extensive cell destruction, as seen in transfusion reactions involving incompatible blood types.
We conclude our extensive exploration of the cellular and molecular biology of the immune response by emphasizing studies that unveil the dynamic choreography of immune cells within living tissues. These images and videos have not only validated predictions made by immunologists who previously lacked the tools to visualize the cells they studied but have also uncovered unexpected characteristics of immune cells: the striking swarming behavior of neutrophils, the intricate dendritic processes of germinal center B cells, the coordinated interactions of B- T-cell pairs at the follicular boundary, and the distinctive appearance and activity of resident memory T cells in barrier tissues, to name just a few. The chapter concludes with an introduction to studies examining immune cell behavior in pathological conditions, which will serve as the foundation for the next series of chapters focusing on the dual role of immune cells in both combating and contributing to disease.
The barrier immune systems, comprising tissues and cells in the intestinal, respiratory, reproductive, and urinary tracts (mucosal-associated lymphoid tissue or MALT), as well as in the skin, play a crucial role in monitoring and protecting areas of the body exposed to the external environment. Epithelial cells form the first line of innate immunity, with each barrier tissue covered by one or more epithelial layers that collaborate other innate and adaptive immune cells. This coordination fosters a harmonious relationship with the diverse community of microorganisms inhabiting our bodies. The interaction between the microbiome and the immune system strengthens the integrity of epithelial barriers and creates optimal conditions for defending against harmful pathogens. While each barrier tissue has unique characteristics, they share common strategies to promote tolerance to commensal microorganisms through the maintenance of regulatory T cells and IgA-producing B-cell activity, alongside mechanisms that initiate type 1 and type 2 inflammatory responses against organisms that harm barrier tissues. Achieving the delicate balance between tolerance and an inflammatory response to microbes remains a core challenge, addressed through various molecular and cellular immune strategies that are only beginning to be understood.
The adaptive immune system is renowned for its vast diversity of antibody and T-cell receptor specificities. The mechanisms generating this diversity—V(D)J recombination and somatic hypermutation—are unique and highly regarded by scientists in various biological fields. However, another crucial aspect of diversity often overlooked by those outside immunology is the extensive range of immune effector mechanisms, both antibody- and cell-mediated, that provide protection. For humoral responses, this diversity in the biological properties of antibodies—including structural variations, mechanisms for pathogen elimination, ability to traverse tissue layers into different body fluids, resistance to degradation, and longevity in circulation—stems from sequence variation in the constant regions of heavy chain classes and subclasses. These differences evolved in vertebrates due to the adaptive advantage of producing antibodies capable of neutralizing pathogens and targeting infected or tumor cells through multiple mechanisms. These mechanisms include neutralizing and agglutinating antigens, enhancing phagocytosis via opsonization, activating complement pathways leading to cell lysis, inducing antibody-dependent cell-mediated cytotoxicity, and triggering degranulation and mediator release. To enable the generation of antibodies with such diverse functions, the immune system developed a third unique gene-altering process known as heavy-chain class switch recombination (CSR). CSR allows naïve B cells with IgM and IgD B-cell receptors to produce antibody-secreting plasma cells capable of generating antibodies of other classes better suited to combat an invading pathogen. As previously discussed, the regulation of the heavy chain ultimately expressed in an activated B cell reflects this remarkable adaptability.
B cells are defined by the presence of a membrane-bound immunoglobulin receptor, which binds antigens. Upon antigen binding and receiving auxiliary signals, B cells are directed to secrete soluble antibody molecules. There are four main subsets of B cells—B-1a, B-1b, B-2 (follicular), and marginal zone (MZ) B cells—distinguished by their anatomical locations, the antigens they recognize, and their dependence on T-cell help. B-1 B cells predominantly protect body cavities, especially the peritoneal cavity. They can produce antibodies upon antigen stimulation without requiring T-cell help, though T-cell-derived signals can enhance their responses. B-1 B cells are self-renewing in the periphery and primarily secrete IgM antibodies, many of which target carbohydrate antigens. B-1a and B-1b cells are differentiated by the expression of CD5 molecules on B-1a cells. Marginal zone B cells reside in the spleen's marginal zones and are particularly adept at responding to TI-2 antigens. The strategic positioning of B-1 and MZ B-cell subpopulations at antigen entry sites, along with their oligoclonality and cross-reactivity to various microbes, situates them at the interface of innate and adaptive immunity.B-2 (follicular) B cells are the most prevalent B-cell subset and require assistance from CD4 T cells to respond to antigens. Early in an immune response, B-2 B cells can differentiate into IgM-secreting plasma cells and IgM-bearing memory cells. They also undergo class switch recombination, a process that depends on CD4 T-cell help. Some B-2 B cells migrate into follicles and develop into germinal center B cells, where they collaborate with T cells to undergo somatic hypermutation and antigen-driven selection. These processes result in the production of high-affinity antibodies.
The initial critical challenge in B-cell development is the creation of B cells with an extensive repertoire—billions of B-cell receptor specificities—capable of responding to virtually any foreign element entering the body. The diversity of antibodies, arising from gene rearrangements, junctional diversification, and various combinations of heavy and light chains, is further enhanced by the daily production of millions of new B cells. Unnecessary B cells are replaced by new ones generated in the bone marrow through hematopoiesis and B-cell development processes. Progression through hematopoietic stages, commitment to the lymphoid lineage, and early B-cell development in the bone marrow, leading to the formation of immature B cells, is regulated by transcription factor networks. Of particular significance is the E2A → EBF1 → PAX5 transcription factor cascade, a feed-forward regulatory mechanism where PAX5 activates the genes defining the B lymphocyte phenotype, which remains unchanged until antigen and other signals prompt differentiation into antibody-secreting plasma cells. This intricate transcription factor network is influenced by, and influences, numerous epigenetic modifications controlling the gene transcription and protein expression unique to each stage. The precise and successful recombination of heavy and light-chain genes is integral to, and sometimes drives, the progression through B-cell developmental stages, with checkpoints ensuring proper rearrangements that yield functional BCRs. Following V-DJ recombination, the µ heavy chain undergoes testing to confirm its ability to pair and associate with the surrogate light-chain polypeptide; if successful, the resulting pre-BCR provides the necessary signals for further development.